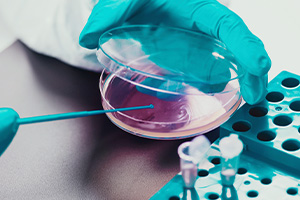

ΥΠΗΡΕΣΙΕΣ
Μερικές από τις εξετάσεις που πραγματοποιούνται στο εργαστήριο
ΑΙΜΑΤΟΛΟΓΙΚΟ ΤΜΗΜΑ
Γενική αίματος
Μικροσκοπική μελέτη επιχρίσματος περιφερικoύ αίματος
Ηλεκτροφόρηση αιμοσφαιρίνης
Διαταραχές πήξης
Διερεύνηση αναιμίας κ.α
ΒΙΟΧΗΜΙΚΟ
Έλεγχος διαβήτη
Δείκτες ηπατίτιδας
Δείκτες ηπατικής, νεφρικής λειτουργιάς
Ηλεκτρολύτες
Επίπεδα φαρμάκων
Δείκτες οστεοπόρωσης κ.α
ΟΡΜΟΝΟΛΟΓΙΚΟ ΤΜΗΜΑ
Έλεγχος προστάτη
Έλεγχος θυρεοειδικής λειτουργιάς
Έλεγχος υπογονιμότητας
Βιταμίνες
ΜΙΚΡΟΒΙΟΛΟΓΙΚΟ ΤΜΗΜΑ
Καλλιέργειες κολπικού επιχρίσματος
Καλλιέργεια σπέρματος
Σπερμοδιάγραμμα
ΑΝΟΣΟΛΟΓΙΚΟ ΤΜΗΜΑ
Καρκινικοί δείκτες
Έλεγχος αυτοάνοσων νοσημάτων
Ηλεκτροφορήσεις
ΜΟΡΙΑΚΟ ΤΜΗΜΑ
Μοριακός έλεγχος COVID -19,
Μοριακός έλεγχος ιού ηπατίτιδας C
Μοριακός έλεγχος ιού ηπατίτιδας Β
Έλεγχος θρομβοφιλίας
ΑΛΛΕΡΓΙΟΓΟΝΑ
ΜΙΚΡΟΒΙΟΛΟΓΙΚΟ ΕΡΓΑΣΤΗΡΙΟ
Ένα σύγχρονο εργαστήριο πιστοποιημένο με ISO 9001.Διαθέτει τελευταίας τεχνολογίας εξοπλισμό για την εκτέλεση όλων των διαγνωστικών εξετάσεων .
Οι στόχοι μας είναι δυο.
- Το αξιόπιστο αποτέλεσμα το οποίο θα αποτελέσει πολύτιμο εργαλείο για τη διάγνωση, πάντα προς όφελος του ασθενή.
- Η προσωπική επικοινωνία του ιατρού με τον ασθενή , ο όποιος είναι διαθέσιμος να λύσει οποιαδήποτε απορία σχετικά με τα εργαστηριακά αποτελέσματα.
ΤΟ ΕΡΓΑΣΤΗΡΙΟ
Διενεργεί εσωτερικούς και εξωτερικούς ποιοτικούς ελέγχους για τη διασφάλιση της ποιότητας των αποτελεσμάτων
Έχει τη δυνατότητα για αιμοληψία κατ’ οίκων
Έχει τη δυνατότητα αποστολής των αποτελεσμάτων με email
Έχει άνετο ,φιλικό και προσιτό χώρο που διαμορφώθηκε με σκοπό την απαγκίστρωση από τα γνωστά ιατρικά πρότυπα με σκοπό την ευχάριστη παραμονή σας.
ΠΡΟΣΦΟΡΕΣ ΜΙΚΡΟΒΙΟΛΟΓΙΚΟΥ
ΛΙΠΙΔΑΙΜΙΚΟΣ ΕΛΕΓΧΟΣ
Χοληστερίνη
Τριγλυκερίδια
HDL
LDL
ΕΛΕΓΧΟΣ ΣΑΚΧΑΡΩΔΗ ΔΙΑΒΗΤΗ
Σάκχαρο
ΗbA1c
ΒΑΣΙΚΟ CHECK UP
Γενική αίματος
Σάκχαρο
Ούρια
Κρεατίνη
SGOT,SGPT
Χοληστερίνη
Τριγλυκερίδια
ΕΛΕΓΧΟΣ ΘΥΡΟΕΙΔΗ
TSH
T3,T4
EΛΕΓΧΟΣ ΠΡΟΣΤΑΤΗ
PSA
ΕΛΕΓΧΟΣ ΒΙΤΑΜΙΝΩΝ
Β12
Φυλλικό οξύ
Βιταμίνη D3
ΚΑΛΛΙΕΡΓΕΙΕΣ
Καλ. ουρων, γενική ουρών, αντιβιόγραμμα
Καλ. σπέρματος , σπερμοδιάγραμμα
ΕΛΕΓΧΟΣ ΑΝΑΙΜΙΑΣ
Γενική αίματος
Σίδηρος
Φερριτίνη